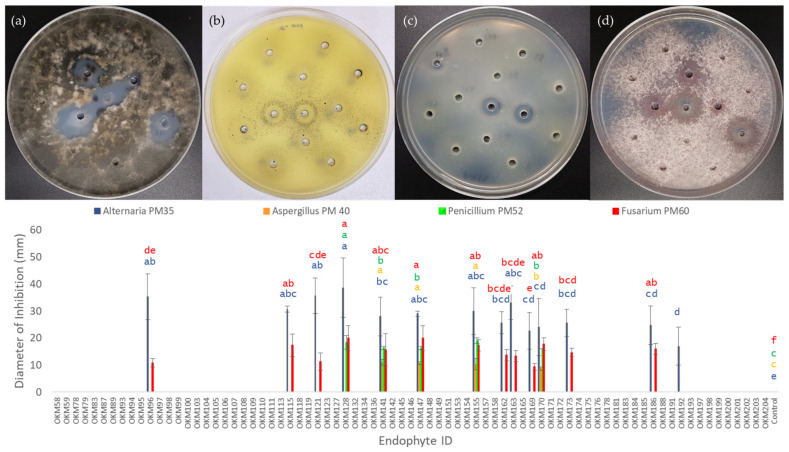
PMC9415172 – plants-11-02127-f005

Cannabis Seedlings Inherit Seed-Borne Bioactive and Anti-Fungal Endophytic Bacilli
Abstract
Throughout the hundreds of millions of years of co-evolution, plants and microorganisms have established intricate symbiotic and pathogenic relationships. Microbial communities associated with plants are in constant flux and can ultimately determine whether a plant will successfully reproduce or be destroyed by their environment. Inheritance of beneficial microorganisms is an adaptation plants can use to protect germinating seeds against biotic and abiotic stresses as seedlings develop. The interest in Cannabis as a modern crop requires research into effective biocontrol of common fungal pathogens, an area that has seen little research. This study examines the seed-borne endophytes present across 15 accessions of Cannabis grown to seed across Western Canada. Both hemp and marijuana seedlings inherited a closely related group of bioactive endophytic Bacilli. All Cannabis accessions possessed seed-inherited Paenibacillus mobilis with the capacity to solubilize mineral phosphate. Additionally, seeds were found to carry genera of fungal isolates known to be Cannabis pathogens and post-harvest molds: Alternaria, Penicillium, Cladosporium, Chaetomium, Aspergillus, Rhizopus, and Fusarium. Thirteen seed-borne endophytes showed antibiotic activity against Alternaria, Aspergillus, Penicillium, and Fusarium. This study suggests both fungal pathogens and bacterial endophytes that antagonize them are vectored across generations in Cannabis as they compete over this shared niche.
Article type: Research Article
Keywords: endophyte, biocontrol, bacillus, fusarium, alternaria, aspergillus, penicillium, damping-off, biological mediated management, pathogens
License: © 2022 by the authors. CC BY 4.0 Licensee MDPI, Basel, Switzerland. This article is an open access article distributed under the terms and conditions of the Creative Commons Attribution (CC BY) license (https://creativecommons.org/licenses/by/4.0/).
Article links: DOI: 10.3390/plants11162127 | PubMed: 36015430 | PMC: PMC9415172
Relevance: Relevant: mentioned in keywords or abstract
Full text: PDF (3.5 MB)
1. Introduction
Plants can adapt to their environment by hosting beneficial bacteria and fungi that confer selective advantages to their host in stressed conditions [ref. 1]. These microorganisms can contribute to overall plant health by assisting in nutrient acquisition, secreting plant-growth-promoting phytohormones, eliciting host immune responses, or antagonizing pathogens to prevent disease [ref. 1,ref. 2,ref. 3,ref. 4]. Microorganisms that exist within plants are known as “endophytes”, and current research has elucidated how important these microorganisms are with respect to plant health [ref. 5,ref. 6]. The internal spaces of plants are unsurprisingly ideal habitats for many microorganisms: with a rich supply of carbon and other nutrients, as well as protection from harsh environments, plants host vast communities of microorganisms that can have a beneficial or pathogenic effect on their host [ref. 1,ref. 2,ref. 3,ref. 4,ref. 7].
In addition to the microorganisms obtained from the environment, plants inherit a founding microbiome via seed-to-seedling vertical transmission [ref. 8]. Developments in our understanding of the seed microbiome and its role in plant ecology have been slow in comparison to that of the interaction with soil, the rhizosphere, and the plant microbiome as a whole [ref. 9]. Seed-borne microorganisms are of particular interest as they act as the starting point for the assemblage of new microbial communities for germinated seedlings during this critical stage in the plant life cycle [ref. 10].
Research suggests that the microbial communities associated with seeds planted in soil originate primarily from the mother plant rather than from their soil environment [ref. 11,ref. 12]. This seed microbiome is an important source of inoculum for developing seedlings, and plants appear to place strong selective forces on seed-borne microorganisms over soil-borne microorganisms during germination by shaping what species proliferate and colonize emerging seedlings [ref. 7]. Microorganisms that have effectively colonized plant tissues have the potential to exert a “barrier effect” against other microorganisms, preventing their colonization [ref. 13,ref. 14]. This potentially explains why seed-borne microorganisms, especially endophytes, are not simply overtaken by the ocean of soil-borne microorganisms and can persist across plant generations [ref. 15].
Soil is a well-established driver of the composition of plant-associated microbial communities. However, understanding of the role for seed-borne microorganisms in the plant life cycle has grown substantially throughout the past decade [ref. 9]. While research has suggested that the bacterial communities of rhizospheres are primarily influenced by the surrounding soil [ref. 16], there is also evidence that microbial inheritance plays an important role in forming early rhizosphere communities. One such study found that while soil type was the main driver of bacterial group structure in the rhizosphere, the most common bacterial cells (Proteobacteria and Bacteroidetes) in juvenile maize rhizospheres across three soil types appeared to be seed-derived. [ref. 17]. These results are further supported by a recent study showing that soil adds microbial diversity to early plant rhizospheres, while seeds contribute the most abundant bacteria found during the early stages of a plant’s life cycle [ref. 12].
This phenomenon of microbial inheritance appears to play a major role in determining microbial communities in plant endospheres [ref. 18]. Bacterial endophytes of maize have been suggested to be primarily seed-borne rather than originating from their soil environment [ref. 18]. Given that this phenomenon of microbial inheritance appears to play a major role in determining microbial communities in plant endospheres, it is interesting to speculate about alternative systems outside of genetics by which selective advantages are inherited from parental plants. There is potentially selection pressure for microorganisms to be maintained and transmitted to offspring plants to protect them against biotic and abiotic stresses. Researchers have suggested that certain microorganisms can protect developing seedlings from pathogens in their new environment by altering seedling redox status [ref. 19]. Furthermore, a diversity of seed endophytes isolated from cucurbit species showed antibiotic activity against common greenhouse pathogens such as powdery mildew and Pythium [ref. 6,ref. 20]. It is clear that plants and microorganisms have co-evolved over hundreds of millions of years and that plants have selected for symbionts that are vertically transmitted across generations to provide a selective advantage to germinating seedlings [ref. 9,ref. 12].
The emerging global Cannabis market is predicted to reach 30 billion USD by 2025 [ref. 21] and the demands of growing a new crop on this scale will present an array of problems that require creative and sustainable solutions. Given the nature of the market, little research has been done on Cannabis cultivation relative to other crops, and so there are many opportunities to answer important questions that will benefit growers in Canada and around the world. Cannabis growers are challenged by an array of fungal pathogens with the potential to destroy entire harvests. Furthermore, synthetic fungicides are forbidden for both recreational and medicinal Cannabis in Canada and California (https://bit.ly/2BMfIYt (accessed on 1 March 2021), https://bit.ly/2OkvT4T (accessed on 1 March 2021). Consumer demand for safe, organically grown Cannabis products means that growers need effective biocontrol agents for fungal pathogens, an area that has seen little research in Cannabis.
Recent research on pathogens of Cannabis has documented what growers have struggled with long before the recent legalization of Cannabis in Canada: roots and stems of Cannabis plants are commonly infected by species of Fusarium and Pythium [ref. 22,ref. 23,ref. 24], both of which cause wilting and stem rot—symptoms colloquially known as “damping off”. The dominant foliar pathogen associated with Cannabis tissue is Golovinomyces cichoracearum, which causes powdery mildew [ref. 23]. Although this pathogen can also infect stems and flowers, it most commonly presents itself as white powdery mycelial growth on leaves [ref. 25]. The revived interest in Cannabis is primarily driven by the secondary metabolites produced in flowering tissue. Cannabis female inflorescences (commonly known as “buds”) are infected by several pre- and post-harvest pathogens with the potential to make the final product unusable. Botrytis, Penicillium, and Fusarium are causes of “bud rot” in both pre- and post-harvest tissues [ref. 25,ref. 26]. Species of well-studied plant pathogens, Cladosporium, Alternaria, and Aspergillus, have also been isolated from flower tissue grown indoors and in greenhouses [ref. 23,ref. 25]. These genera of flower-infecting fungi are known to have toxigenic species that produce mycotoxins that cause illness, or, at the very least, lead to quality control failures [ref. 27,ref. 28].
In general, microbial inheritance via seed-to-seedling vertical transmission occurs through microbial colonization of external and internal seed tissue in developing flowers [ref. 29,ref. 30]. In fact, microscopic analysis shows that the inner surface of flower petals is densely populated by a diversity of bacteria, including species that show biocontrol activity [ref. 31]. These species are in close contact on the surface of the seed coat and have the potential to be passed down to developing seedlings as they germinate [ref. 9]. Given that a diversity of fungal pathogens readily colonize Cannabis flowers both pre-and post-harvest, we hypothesize that Cannabis seeds vector opportunistic fungal pathogens as well as bacterial symbionts that protect them against biotic and abiotic stresses as they germinate into seedlings. Throughout our report, the mature Cannabis fruits (achenes) are referred to as “seed” for simplicity and because they are commonly referred to as such in the hemp and marijuana industry. This whole Cannabis fruit is what is typically sown in fields or naturally shed from Cannabis plants when ripe [ref. 32,ref. 33] and so is analogous to seeds of other crops in the context of seed-borne microorganisms [ref. 12].
The objective of this study is to (1) survey seed-borne endophytes found inside juvenile Cannabis seedlings. A selection of 15 accessions of hemp and marijuana types were grown to maturity in different locations across Western Canada before seeds were germinated in the absence of environmental microorganisms. A total of 136 bacterial isolates were cultured, identified, and (2) phenotyped for their capacity to solubilize mineral phosphate, secrete indole-3-acetic acid (IAA), and hydrolyze pectin. A selection of unique isolates from each accession (78 endophytes) were then tested for their ability to (3) antagonize seed-borne fungi that had been isolated from germinating Cannabis seeds. We demonstrated that the Cannabis accessions in this study inherited a conserved group of Bacilli with bioactivites that included suppression of fungal growth. This study suggests co-evolution between Cannabis and vertically transmitted, endophytic Bacilli.
2. Results
2.1. Cannabis Seedlings Inherit Seed-Borne Endophytic Bacilli
We germinated seeds from 15 different accessions of Cannabis including both hemp and marijuana types (Figure 1a). These seeds were germinated in sterile Petri plates, and the culturable endophytes within the germinated seedlings were identified (Figure 1b). Because the culture environment had been sterilized, the endophytes present inside seedling tissue must have been acquired from the seed surface and seed endosphere [ref. 12]. Prior to detection of endophytes, all seedlings were tested for surface sterility by plating a final wash onto nutrient agar; no growth was observed on any plate, which confirms that seedling surfaces were sterile. A total of 136 bacterial isolates were obtained from the seedling endosphere and were assigned to taxa using 16S sequencing. Although the seeds came from four different locations and growing conditions in Canada, we observed unexpected conservation of some of the culturable, seed-borne seedling endophytes (Table 1). Moreover, seeding endospheres of these 15 Cannabis accessions appeared to be dominated by endospore-forming bacteria in the class Bacilli. Notably, Paenibacillus mobilis isolates were cultured from endospheres of 100% (15/15) of accessions, despite the different conditions in which their mother plants were grown (Figure 1a). The well-studied and agriculturally important soil bacterium, Bacillus subtills, was found in the majority (8/15) of Cannabis accessions, and was present in both hemp and marijuana.

Table 1: Culturable Seed-borne Endophytes from Seedling Endospheres. Green shaded cells indicate isolation from pool of 5 seedlings following germination in sterile environment and surface sterilization.
| Seed-Borne Seedling Endophytes | Hemp Cultivars | Marijuana Cultivars | Flax | |||||||||||||
|---|---|---|---|---|---|---|---|---|---|---|---|---|---|---|---|---|
| Field | Field | Field | Field | Field | Field | Field | Field | Field | Indoor | Indoor | Indoor | Indoor | Indoor | Indoor | Field | |
| Bacterial Species | Altair | Alyssa | CAN 3797 | Canda | FIN34 | Grandi | Katani | LKCSD | X-59 | X-59 Gen 2 | Afghani | BC Big Bud | God’s Bud | God’s Pink | White Widow | Bethune |
| Bacillus aerius | ||||||||||||||||
| Bacillus circulans | ||||||||||||||||
| Bacillus ginsengihumi | ||||||||||||||||
| Bacillus inaquosorum | ||||||||||||||||
| Bacillus megaterium | ||||||||||||||||
| Bacillus stratosphericus | ||||||||||||||||
| Bacillus subtilis | ||||||||||||||||
| Bacillus velezensis | ||||||||||||||||
| Bacillus wiedmannii | ||||||||||||||||
| Bacillus zhangzhouensis | ||||||||||||||||
| Bacillus simplex | ||||||||||||||||
| Brevibacillus choshinensis | ||||||||||||||||
| Paenibacillus azotifigens | ||||||||||||||||
| Paenibacillus humicus | ||||||||||||||||
| Paenibacillus illinoisensis | ||||||||||||||||
| Paenibacillus mobilis | ||||||||||||||||
| Paenibacillus pabuli | ||||||||||||||||
| Paenibacillus polymyxa | ||||||||||||||||
| Paenibacillus senegalensis | ||||||||||||||||
| Paenibacillus sinopodophylli | ||||||||||||||||
| Paenibacillus taohuashanense | ||||||||||||||||
| Paenibacillus terreus | ||||||||||||||||
| Paenibacillus vulneris | ||||||||||||||||
| Paenibacillus yunnanensis | ||||||||||||||||
| Pantoea agglomerans | ||||||||||||||||
| Psychrobacter pulmonis | ||||||||||||||||
Seed from field-grown flax, Linum usitatissimum var.Bethune, was included in this experiment as an out-group for comparison and as a control for contamination. Only one culturable seed-borne endophyte, Bacillus megaterium, was isolated from flax seedlings (Table 1). This bacterium was found in 47% of the Cannabis genotypes (7/15). Seed-borne Paenibacillus mobilis was not isolated from any flax endospheres in our experiments.
Phylogenetic analysis of the 16S gene from the 136 seed-borne Cannabis bacterial endophytes further demonstrated that a large number of the culturable bacterial taxa that colonize Cannabis seedling endospheres are well-conserved across seed accessions (Figure 2). Endophytes belonging to the genera Bacillus (28.26%) and Paenibacillus (67.39%) made up the majority of isolates. Bacillus endophytes were isolated from 80% of Cannabis genotypes, while endophytes belonging to the genus Paenibacillus were isolated from all 15 (100%) Cannabis accessions. In the absence of environmental microorganisms, the Cannabis genotypes in this study appeared to inherit a group of closely related endophytes from parental seed. Details on all isolates obtained from the seed-borne endospheres can be found in Supplementary Table S1.

Hemp variety X59 was represented in our analysis by two samples from two different generations, grown under different conditions. The first generation (X59 Gen-1) was produced by field-grown plants in Vegreville, Alberta. Some of these seeds were subsequently sown in soilless commercial potting mix and grown to maturity indoors in Kelowna, British Columbia, and the seeds produced by these plants were labeled X59 Gen-2. Analysis of endophyte 16S amplicons showed that the strains of Bacillus megaterium and Paenibacillus mobilis isolated from seedling endospheres across these generations were identical despite growing in vastly different environments (Supplementary Figure S1).
2.2. Endophyte Phosphate Solubilization
Plants have been known to harbor root endophytes that secrete organic acids to solubilize rock phosphate in the surrounding environment. Seed-borne Cannabis endophyte isolates were assessed for their ability to solubilize mineral phosphate by growing on tricalcium phosphate media and creating clear halos around the culture—interestingly, phosphate-solubilizing bacteria were isolated from the endosphere of all 15 Cannabis accessions (100%). In total, 10 different bacterial species were found to solubilize phosphate. Ubiquitous across all Cannabis seedings in this study was phosphate-solubilizing Paenibacillus mobilis (Figure 3).

2.3. Endophyte Indole-3-Acetic Acid Activity
Plant-associated bacteria have been known to secrete phytohormones that interact with their host plant with the potential to modulate plant growth. Microbial production of the auxin, indole-3-acetic acid (IAA), can promote root growth and colonization, and circumvent plant immune responses [ref. 34,ref. 35]. Cannabis endophytes were assayed for in vitro IAA production and secretion using a colorimetric assay [ref. 36]. IAA production was detected in six different bacterial species isolated from 53.3% (8/15) of Cannabis accessions in this study (Figure 3).
2.4. Endophyte Pectinase Activity
Pectin is a structural heteropolysaccharide that is a major component of plant cell walls. Pectinase activity of seed-borne Cannabis endophytes was assessed by growing on agar supplemented with citrus pectin and visualizing halos by staining with Gram’s Iodine. Pectinase activity was found in four different bacterial species across five Cannabis accessions (33%) (Figure 3). Pectinase activity was limited to endophytes of hemp, as no marijuana accessions hosted species with this phenotype.
2.5. Seed-Borne Fungi
Seedling endospheres are expected to harbor fungi [ref. 10]. However, following seedling surface sterilization, only a single accession of either Cannabis or flax produced culturable fungus on PDA with tetracycline. This isolate was obtained from the God’s Bud accession and was identified as PM17- Penicillium (Supplementary Table S1). In contrast, bacterial endophytes were cultured from seedling endospheres of every accession, totaling 136 bacterial isolates.
Seeds are a well-known vector of both fungal symbionts and pathogens in many plant species [ref. 28,ref. 37,ref. 38]. The absence of fungi from surface-sterilized seedlings does not imply that they are absent from seeds and seedling surfaces. Therefore, Cannabis accessions were examined without seedling surface sterilization where seeds were instead directly germinated on PDA with tetracycline to assess germination and presence of seed-associated fungi. In this experiment, “VIR577” was substituted for “God’s Pink” due to availability of seeds.
Fungal isolates were cultured from seeds/seedlings of 73.3% (11/15) of Cannabis accessions. From each accession, morphologically unique colonies were subcultured and identified by ITS region sequencing. A total of 24 seed-associated fungal isolates were found from this experiment (Figure 4a). Of interest, 83.3% (20/24) of these isolates were identified as genera of known Cannabis pathogens and post-harvest molds: Alternaria, Penicillium, Cladosporium, Chaetomium, Aspergillus, Rhizopus, and Fusarium. The germination rates and number of seeds engulfed by mycelia (disease pressure) in this experiment can be seen in Figure 4b. Notably, there were large fluctuations in the germination rates of the various Cannabis accessions as well as three cultivars with 100% germination and 0% of seeds with any fungal disease pressure: Afghani, Alyssa, and White Widow.

2.6. Endophyte Anti-Fungal Activity
A total of 78 seed-borne bacterial endophytes were selected based on unique taxonomies from each accession of Cannabis in this study. These isolates were tested for their ability to antagonize growth of four different seed-borne fungi belonging to genera of known Cannabis pathogens: Alternaria PM35, Aspergillus PM40, Penicillium PM52, and Fusarium PM60 (Figure 5). Thirteen bacterial isolates covering four different species were found to have anti-fungal properties and were capable of creating zones of inhibition when co-cultured on PDA with these fungi. Anti-fungal activity was found in bacterial isolates from 60% (9/15) of the Cannabis accessions examined in this study. A summary of these data can be seen in Table 2.
Table 2: Summary of Anti-fungal Activity in Seed-borne Cannabis Endophytes.
| Strain ID | Taxonomy | Accession | Host | Antagonizes |
|---|---|---|---|---|
| OKM96 | Bacillus inaquosorum | BC Big Bud | Marijuana | Alternaria |
| OKM115 | Bacillus subtilis | BC Big Bud | Marijuana | Alternaria, Fusarium |
| OKM121 | Bacillus subtilis | God’s Bud | Marijuana | Alternaria, Fusarium |
| OKM128 | Bacillus subtilis | CAN 3797 | Hemp | Alternaria, Fusarium, Penicillium |
| OKM141 | Bacillus velezensis | CAN 3797 | Hemp | Alternaria, Aspergillus, Fusarium, Penicillium |
| OKM147 | Paenibacillus polymyxa | Altair | Hemp | Alternaria, Aspergillus, Fusarium, Penicillium |
| OKM155 | Paenibacillus polymyxa | Katani | Hemp | Alternaria, Aspergillus, Fusarium, Penicillium |
| OKM162 | Bacillus subtilis | Grandi | Hemp | Alternaria, Fusarium |
| OKM163 | Bacillus subtilis | Altair | Hemp | Alternaria, Fusarium |
| OKM169 | Bacillus subtilis | LKCSD | Hemp | Alternaria, Fusarium |
| OKM170 | Paenibacillus polymyxa | FIN34 | Hemp | Alternaria, Aspergillus, Fusarium, Penicillium |
| OKM173 | Bacillus subtilis | FIN34 | Hemp | Alternaria, Fusarium |
| OKM186 | Bacillus subtilis | Alyssa | Hemp | Alternaria, Fusarium |
Alternaria PM35 (Figure 5a) was the fungal isolate that was antagonized by the largest number of bacterial isolates tested, with 13 bacterial isolates inhibiting Alternaria PM35. Bacillus subtills OKM128 was the strongest antagonist and created an average zone of inhibition equal to 38.6 ± 11.02 mm in diameter after 7 days of co-culturing. In contrast, Aspergillus isolate PM40 (Figure 5b) was inhibited by only four of the bacterial isolates tested, making it the fungus that showed the highest level of resistance in this study (Table 2). Anti-Aspergillus isolates were limited to the species Paenibacillus polymyxa and Bacillus velezensis; the largest average zone of inhibition was 11.0 ± 1.0 mm from Bacillus velezensis OKM141. Five isolates comprising three different species were able to antagonize Penicillium PM52: Bacillus subtilis, Paenibacillus polymyxa, and Bacillus velezensis. Bacillus subtills OKM128 produced, again, the largest zone of inhibition with an average diameter of 18.33 ± 2.5 mm. Zones of inhibition against Fusarium PM60 were produced by 12 isolates (three different species), the greatest of which was an average of 17.67 ± 2.3 mm by Paenibacillus polymyxa OKM170. All negative controls (uninoculated TSB liquid medium) showed no zones of inhibition, with fungal hyphae growing over holes in agar. ANOVA and Tukey’s HSD test for significance were conducted across bacterial isolates (including negative control) for antagonism of each fungus. Letter values (Figure 5) were assigned to means to distinguish groups significantly different from one another (α = 0.05).
3. Discussion
Plant microbiome research has been heavily focused on the role of soil on microbial community structure. Until recently, the dominance of seed-borne microorganisms in early community establishment was poorly understood. New research demonstrates that seed-borne microorganisms are the primary colonizers of juvenile angiosperms, and soil microorganisms only colonize young plants efficiently when the seed microbiome is disrupted by surface sterilization [ref. 12,ref. 39]. Importantly, most previous research on the contributions that plant genotype, seed microorganisms, and soil communities have on the plant microbiome has used surface-sterilized seeds, disrupting spermosphere/seed-coat microorganisms that play an important role in vertical transmission [ref. 40]. As has been done in more current studies, we deliberately did not surface sterilize Cannabis seeds, prior to seedling surface sterilization, to avoid artificially disrupting seed-surface microorganisms that may be heritable [ref. 9,ref. 12,ref. 18,ref. 39]. Despite the diverse geographic origins of seed production, Cannabis seedlings in this study, when germinated in the absence of environmental microbes, inherited a closely related group of endophytic Bacilli with a variety of interesting phenotypes that may benefit seeds as they germinate in a new environment (Table 1, Figure 3).
The phenomenon of microbial inheritance is well-studied in many plant species [ref. 10]. Our report documents this process in Cannabis and identifies some of the relevant functions of seed-borne seedling endophytes. To further support the previous observation, a second generation of the hemp cultivar X59 was grown to maturity to produce seed indoors in Sunshine soil mix (Sun Gro Horticulture, Agawam, MA, USA) at the University of British Columbia, Okanagan. This environment differs greatly from the outdoor fields, where X59 generation-1 was grown to maturity to produce seed at InnoTech Alberta (Figure 1). The clear preservation of two identical species of seed-borne endophytes across this generation suggests that X59 (and Cannabis in general) selects for certain microorganisms to be maintained in its microbiome and passed down subsequent plant generations (Supplementary Figure S1). Other plants such as rice and corn have conserved and vertically transmitted core microbial groups that appear to be maintained across generations from ancestral relatives to modern cultivars [ref. 41,ref. 42]. Future studies should investigate what core microbial species are found in Cannabis seeds throughout its evolution, domestication from the Himalayan foothills of central Asia, and thousands of years of cultivation [ref. 43,ref. 44]. Such a study would rely on improved phylogenetic classification of ancestral, landrace, and modern Cannabis accessions grown today, an area that is currently being researched [ref. 45].
All 15 accessions of Cannabis, including hemp and marijuana, inherited seed-borne Paenibacillus mobilis with the capacity to solubilize mineral rock phosphate. The out-group flax cultivar, Bethune-0, did not harbor this species of phosphate-solubilizing Paenibacillus mobilis (Figure 3). Phosphate is a vital macronutrient and plants have been documented to host endophytic bacteria in root zones that secrete organic acids that solubilize mineral phosphate, increasing bioavailability, and promoting root growth [ref. 2,ref. 46,ref. 47]. Of note, an endophyte was isolated from seeds of a wild maize relative growing in a volcanic swamp with high levels of insoluble mineral phosphate, and was likely selected to be vertically transmitted across plant generations to assist seedlings in this harsh environment [ref. 2]. The observation that all accessions of Cannabis hosted seed-vectored Paenibacillus mobilis with the potential to convert tricalcium phosphate to a more plant-bioavailable form leads to speculation about what selection pressure nature has exerted on Cannabis throughout its evolution and domestication. Indoor and field-grown hemp and marijuana hosted this endophyte. Phosphorous and nitrogen have been documented to be the most important macronutrients contributing to Cannabis flower yield [ref. 48], and phosphorous nutrition can have an effect on cannabinoid profile [ref. 49]; however, research in this area is still developing.
Seed germination and seedling establishment is sensitive to oxidative imbalances. Reactive oxygen species (ROS) act both as an elicitor to release seed dormancy, a defense mechanism against disease, and toxic metabolites when accumulated in plant cells [ref. 50,ref. 51]. These conflicting effects create an “oxidative window for germination” that is tightly controlled by auxin hormone signaling pathways such as IAA to promote healthy germination [ref. 52,ref. 53,ref. 54]. IAA-secreting bacterial endophytes were found in 53.3% of Cannabis accessions examined in this study (Figure 3). Seed-borne endophytic bacteria that produce IAA have previously been documented to alter seedling development in rice [ref. 55]. This same study showed that when these seed-associated bacteria were removed, there were lower levels of ROS as well as a detrimental effect on root hair development and seedling size compared to rice with an intact seed-borne microbiome. It is speculated that the increased ROS production from seed-borne endophytes may also serve to protect seedlings against invading pathogens [ref. 55]. IAA-producing endophytes have been previously isolated from industrial hemp cultivars [ref. 56]. It is unsurprising that the Cannabis accessions examined here, similar to other plants, inherit bacteria that secrete IAA and likely contribute to seedling germination and establishment. Further testing of these endophytes and their effect on seed germination and establishment should be examined.
Hydrolysis of plant cell walls by enzymes such as pectinase, xylanase, and cellulase is thought to be a mechanism by which some endophytes gain entry into plant tissues [ref. 57]. A small number of bacteria in this study were able to grow on and hydrolyze citrus pectin (Figure 4). Further testing of this library of endophytes should examine other cellulolytic enzyme activity, as well as other sources of pectin. It should be noted that citrus pectin has been documented to have powerful antibiotic activity against both gram-negative and gram-positive bacteria [ref. 58]. There appeared to be growth inhibition of many endophytes in the pectinase assay which would lead them to score negative; these endophyte species may well be able to hydrolyze other forms of pectin.
The role of seeds in dispersal of fungal pathogens in Cannabis has not seen extensive research [ref. 59]; however, seed-borne fungal diseases are well-documented in established crops [ref. 28,ref. 37,ref. 38,ref. 60]. This study found that 73.3% (11/15) of Cannabis accessions hosted at least one seed-borne fungal isolate (Figure 4). The observation that 83.3% (20/24) of these isolates were identified as genera of known Cannabis pathogens and post-harvest molds: Alternaria, Penicillium, Cladosporium, Chaetomium, Aspergillus, Rhizopus, and Fusarium, is unlikely a coincidence. Rather, Cannabis seeds likely act as a vector for fungal pathogens to spread and proliferate. Of particular interest is the observation that Penicillium, Fusarium, Cladosporium, Alternaria, and Aspergillus have been previously identified infecting Cannabis flowers [ref. 23,ref. 25,ref. 26]. Isolates belonging to these pathogenic genera account for 70.8% (17/24) of total isolates. Seed-bone Alternaria has also recently been documented as a pathogen of mature Cannabis [ref. 61]. Taken together, this suggests that Cannabis flowers act as an infection point for opportunistic fungi to be vectored across plant generations via seed transmission. Observationally, the fungi isolated here from germinating seeds appeared to colonize and destroy seed and seedling tissue (Supplementary Figure S2); however, further testing must be done to investigate their potentially pathogenic behavior to mature Cannabis plants.
Given the evidence that Cannabis seeds vector both a conserved group of endophytic Bacilli as well as fungi belonging to potentially pathogenic genera, there is likely competition and co-evolution for the shared niche of germinating Cannabis seeds, as well as selection pressure on Cannabis to maintain beneficial microorganisms with biocontrol in their microbiome. Members of class Bacilli produce a variety of antimicrobial secondary metabolites [ref. 62,ref. 63]. The genera Bacillus and Paenibacillus are currently the best characterized for producing lipopeptides and polyketides that have immense commercial value in agriculture for their capacity to antagonize pathogenic fungi and suppress crop disease. A total 60% (9/15) of Cannabis accessions in this study hosted seed-borne endophytic Bacilli that inhibited growth of seed-associated fungi belonging to plant pathogenic genera (Figure 5, Table 2). Four fungal isolates were selected for this assay based on their taxonomy belonging to the genera Alternaria, Aspergillus, Penicillium, and Fusarium. All of these are known plant pathogens and have been documented to infect Cannabis flowers and cause disease in Cannabis plants [ref. 23,ref. 25,ref. 26,ref. 61]. Of the 78 selected endophytes isolated from the 15 Cannabis accessions, 13 isolates showed antagonism against seed-associated Cannabis fungi (Figure 5, Table 2). Four endophytes showed antagonism against all fungi assayed: Bacillus velezensis OKM141, Paenibacillus polyxma OKM147, OKM155, and OKM170. These endophytes will be further studied for their ability to control fungal pathogens in mature Cannabis plants, as well as on seed. Given the observation of highly variable rates of germination, it is interesting to speculate about the contribution of these various fungi to the diminished germination seen in seeds of certain Cannabis accessions (Figure 4b). Seed-borne Fusarium, Penicillium, Rhizopus, and Aspergillus are associated with decreased seed germination in rice [ref. 28]. Future testing of seed-coating anti-fungal bacterial isolates on low-germination seed will be done to investigate antagonism of seed-associated fungal pathogens, and the resulting effect on germination. Additionally, these anti-fungal bacteria will be tested for their capacity to protect seeds by flower and foliar applications and establishment in the subsequent plant generation as seedling endophytes.
A variety of commercial products exist that use beneficial microorganisms to combat plant pathogens. Serenade® was developed by AgriQuest.Inc (now owned by Bayer) and contains a species of Bacillus subtills that produces a variety of antimicrobial lipopeptides. Serenade® is effective at controlling a variety of pathogens including: fungi such as botrytis [ref. 64], powdery mildew [ref. 65], yellow rust [ref. 66] and early blight [ref. 67]; and protists such as clubroot [ref. 68] and the oomycetes Pythium and Rhizoctonia [ref. 69]. Researchers have begun to investigate the potential of Bacillus species to control fungal pathogens and promote plant growth in Cannabis with promising results [ref. 70,ref. 71,ref. 72]. What makes Bacillus and Paenibacillus particularly attractive to commercial farming is their capacity to form desiccation-resistant endospores, allowing formulation and survival as seed coats [ref. 62]. The seed-borne endophyte library generated in this study is dominated by endospore-forming bacteria and so may possess strains with the potential to be useful as seed-coating biologicals in field-grown hemp. Furthermore, drug-type Cannabis (marijuana) is typically clonally propagated to mitigate variation in phenotypes observed when plants are grown from seed [ref. 73,ref. 74,ref. 75,ref. 76]. The results presented here lead to speculations about the different microbiomes of clonally propagated and seed-grown Cannabis plants. Whether these seed-borne anti-fungal seedling endophytes are absent in clonally propagated Cannabis plants would be of interest to growers of this horticultural crop with limited tools for control of fungal pathogens.
In conclusion, this study demonstrates that Cannabis seeds inherit bioactive and anti-fungal Bacilli that colonize seedling endospheres. Additionally, Cannabis seeds appear to be associated with fungi belonging to genera of known floral pathogens, suggesting that fungi may opportunistically use flowers as a transmission route to infect germinating Cannabis seedlings. The production of antimicrobial secondary metabolites that antagonize seed-associated fungi by these bacterial endophytes suggests competition for the shared niche of germinating Cannabis seeds. Taken together, this paper suggests co-evolution and potential symbiosis between Cannabis and seed-borne Bacilli endophytes.
4. Materials and Methods
4.1. Source of Seed
Bethune-0 is from Kernen Farm in Saskatoon. Altair, Alyssa, CAN3797, FIN34, Grandi, Katani, LKCSD, VIR577, and X59 generation-1 are from InnoTech Alberta. Canda is from Triple S Seeds LTD in Grandview, Manitoba. Afghani, BC Big Bud, God’s Bud, God’s Pink, and White Widow are from a commercial supplier in Qualicum Beach, British Columbia. X59 generation-2 was grown to produce seed at UBCO Kelowna, BC, Canada.
4.2. Seed-Borne Cannabis Seedling Endophyte Isolation
An overview of the isolation design can be seen in Figure 1b. Seedling surface sterilization was based on established methods for seeds with modification [ref. 42]. Five seeds of each Cannabis accession were germinated in sterile environments of Petri plates on autoclaved wet paper towel and placed in the dark for 5 days at 20 °C. Once germinated, seedlings were cleaned by washing with filter-sterilized 0.1% triton X for 10 min. Samples were then surface-sterilized by washing with 3% sodium hypochlorite for 20 min. The samples were then drained and rinsed with autoclaved, distilled water, then washed in 70% ethanol for 10 min. The ethanol was removed, and samples were rinsed 5 times with autoclaved, distilled water. To check for surface sterility, 150 μL of the final wash was spread on R2A and PDA, and one piece of tissue per treatment was transiently placed on sterile agar plates, which were all incubated for 10 days at 25 °C. Surface-sterilized seedlings were ground in 2 mL sterile phosphate buffer using a sterile mortar and pestle. An amount of 150 μL of this solution was spread on plates: R2A + 20 μg/mL nystatin, PDA + 20 μg/mL tetracycline, and TSA+ 20 μg/mL nystatin and incubated at 25 °C. Morphologically unique colonies from each Cannabis accession were isolated and subcultured from each media type. Isolates were grown in R2B for 3 days at 25 °C and stored in 20% glycerol at −20 °C.
4.3. Taxonomic Identification by 16S Gene Sequencing
Colony PCR of bacterial isolates was performed on 1 μL of R2B culture using primers 341F and 785R. PCR was conducted with the following settings: initial denaturation at 95 °C for 5 min, followed by 45 cycles of denaturation at 95 °C for 30 s, annealing at 55 °C for 30 s and extension at 72 °C for 1 min; a final extension phase was performed at 72 °C for 10 min. Amplicons were run on a 1% TAE gel to confirm successful amplification prior to sending to BioBasic (Markham) for Sangar Sequencing. Forward and reverse sequences were aligned and consensus sequences were identified using BLAST against the 16S ribosomal RNA sequences database. Highest scoring alignments were assigned as isolate taxonomy. Sequences were submitted to Genbank under accession numbers OP087663-OP087800.
4.4. Phosphate Solubilization Assay
Solubilization of mineral phosphate activity was tested by growing isolates on tricalcium phosphate media (10 g/L glucose, 2 g/L NH4CL, 0.41 g/L MgSO4, 0.295 g/L NaCl, 0.003 FeCl3, 0.7 g/L Ca3HPO4, 12 g/L Agar) and identifying halos around colonies after 3 days of growth at 25 °C [ref. 42,ref. 77]. Glycerol stocks were used to inoculate R2B medium which was grown for 2 days shaking at 20 °C. Cultures were inoculated on tricalcium phosphate media using a 96-pin replicator; this assay was done in triplicate.
4.5. Pectinase Activity
Pectinase activity was tested by growing isolates on R2A media supplemented with 0.2% citrus pectin (#J61021, Alfa Aesar) and 0.1% triton X-100. Glycerol stocks were used to inoculate R2B medium, which was grown for 2 days shaking at 20 °C prior to inoculating pectin media in triplicate using a 96-pin replicator. Pectin plates were placed in the dark at 25 °C for 3 days followed by flooding with Gram’s Iodine, where isolates displaying pectinase activity were surrounded by clear halos [ref. 42].
4.6. IAA Secretion
Indole-3-acetic acid secretion was tested by growing isolates on R2A media supplemented with 5 mM L-tryptophan. Glycerol stocks were used to inoculate R2B media, which was grown for 2 days shaking at 20 °C prior to inoculating tryptophan-supplemented R2A in triplicate using a 96-pin replicator, which was then grown for 2 days at 25 °C. Plates were then covered with a nitrocellulose membrane and placed at 4 °C overnight, allowing for metabolite transfer. Nitrocellulose membranes were then removed from plates and soaked in Salkoski reagent (0.01 M ferric chloride in 35% perchloric acid) for 30 min. Reddish pink halos were visualized on an illuminated background and indicate bacterial IAA production [ref. 36].
4.7. Seed-Borne Fungi from Cannabis Culturing
Five seeds of each Cannabis accession were planted on PDA + 20 μg/mL tetracycline (inhibits bacterial growth), in a biosafety cabinet and incubated for 5 days at 25 °C to allow for germination and/or growth of fungal colonies. Morphologically unique colonies of fungi associated with seeds and seedlings were subcultured and isolated on PDA. Seed germination and number of seeds/seedlings engulfed in fungal colonies were recorded. Fungal isolates were then subject to colony PCR with primers ITS86F and ITS4R using the following settings: initial denaturation at 95 °C for 5 min, followed by 45 cycles of denaturation at 95 °C for 30 s, annealing at 50 °C for 30 s and extension at 72 °C for 1 min; a final extension phase was performed at 72 °C for 10 min. Amplicons were run on a 1% TAE gel to confirm successful amplification prior to sending to BioBasic (Markham) for Sangar Sequencing. Taxonomy was determined by BLAST against the ITS ribosomal RNA sequences database; highest identity alignments were assigned as isolate taxonomy. Amplicon sequences were submitted to Genbank and assigned accession numbers OP18318-OP183206.
4.8. Anti-Fungal Activity of Cannabis Endophytes
Unique bacterial endophytes from each Cannabis accession were selected to assay for anti-fungal activity against seed-borne Cannabis pathogens: Alternaria PM35 from Altair, Aspergillus PM40 from CAN3797, Penicillium PM52 from God’s Bud, and Fusarium PM60 from VIR577 (Supplementary Table S1). Modifying an established assay [ref. 78], bacterial endophytes were streaked on R2A plates from glycerol stocks and grown for 2 days at 25 °C. Single colonies where then used to inoculate TSB liquid medium which was grown at 20 °C for 2 days shaking at 150 RPM.
Fungal cultures were grown on PDA for 5 days prior to harvesting spores by pipetting 1.3 mL sterile 0.1% Tween20 on plates and harvesting by gentle scraping with an L-spreader. An amount of 1 mL of this solution was used to inoculate 2 L of molten PDA cooled to 50 °C, which was poured into 150 mm × 15 mm plates to solidify. A sterilized Pasteur pipette was used to bore 14 holes in each agar plate. An amount of 100 μL of bacteria liquid culture was pipetted into holes into the agar plate. All 78 isolates were tested in triplicate across different agar plates. Uninoculated TSB was used as a control in this experiment. Plates were incubated for 7 days at 25 °C to allow fungi to grow, after which zones of inhibition surrounding bacterial cultures were measured and recorded. Zones with uneven diameters were measured using the shortest distance that bisected the agar hole. Statistical analysis was done using ANOVA and Tukey’s HSD test on RStudio (2021.09.2 + 382). Means not statistically different from each other are denoted by the same letter groups.
References
- D. Johnston-Monje, M.N. Raizada. Plant and Endophyte Relationships: Nutrient Management, 2011
- H.R. Shehata, C. Dumigan, S. Watts, M.N. Raizada. An Endophytic Microbe from an Unusual Volcanic Swamp Corn Seeks and Inhabits Root Hair Cells to Extract Rock Phosphate. Sci. Rep., 2017. [DOI | PubMed]
- C. Hu, M.S. Reddy, H. Wei, P.W. Pare, J. Greer, J.Y. Wu, D.M. Ornitz, W. Yuan, Y. Rao, R.P. Babiuk. Bacterial Volatiles Promote Growth in Arabidopsis. Proc. Natl. Acad. Sci. USA, 2003. [PubMed]
- W.K. Mousa, C. Shearer, V. Limay-Rios, C.L. Ettinger, J.A. Eisen, M.N. Raizada. Root-Hair Endophyte Stacking in Finger Millet Creates a Physicochemical Barrier to Trap the Fungal Pathogen Fusarium Graminearum. Nat. Microbiol., 2016. [DOI | PubMed]
- G. Berg, K. Martina, D. Rybakova, M. Henry, R. Grosch, K. Smalla. Plant Microbial Diversity Is Suggested as the Key to Future Biocontrol and Health Trends. FEMS Microbiol. Ecol., 2017. [DOI]
- E.M. Khalaf, M.N. Raizada. Bacterial Seed Endophytes of Domesticated Cucurbits Antagonize Fungal and Oomycete Pathogens Including Powdery Mildew. Front. Microbiol., 2018. [DOI | PubMed]
- M. Barret, M. Briand, S. Bonneau, A. Préveaux, S. Valière, O. Bouchez, G. Hunault, P. Simoneau, M.A. Jacquesa. Emergence Shapes the Structure of the Seed Microbiota. Appl. Environ. Microbiol., 2015. [DOI | PubMed]
- A. Ferreira, M.C. Quecine, P.T. Lacava, S. Oda, J.L. Azevedo, W.L. Araújo. Diversity of Endophytic Bacteria from Eucalyptus Species Seeds and Colonization of Seedlings by Pantoea Agglomerans. FEMS Microbiol. Lett., 2008. [DOI | PubMed]
- E.B. Nelson. The Seed Microbiome: Origins, Interactions, and Impacts. Plant Soil, 2018. [DOI]
- R. Shahzad, A.L. Khan, S. Bilal, S. Asaf, I.J. Lee. What Is There in Seeds? Vertically Transmitted Endophytic Resources for Sustainable Improvement in Plant Growth. Front. Plant Sci., 2018. [DOI | PubMed]
- L.S. van Overbeek, A.C. Franke, E.H.M. Nijhuis, R.M.W. Groeneveld, U.N. da Rocha, L.A.P. Lotz. Bacterial Communities Associated with Chenopodium Album and Stellaria Media Seeds from Arable Soils. Microb. Ecol., 2011. [DOI | PubMed]
- D. Johnston-Monje, J.P. Gutiérrez, L.A.B. Lopez-Lavalle. Seed-Transmitted Bacteria and Fungi Dominate Juvenile Plant Microbiomes. Front. Microbiol., 2021. [DOI | PubMed]
- M. Bacilio-Jiménez, S. Aguilar-Flores, M.V. Del Valle, A. Pérez, A. Zepeda, E. Zenteno. Endophytic Bacteria in Rice Seeds Inhibit Early Colonization of Roots by Azospirillum Brasilense. Soil Biol. Biochem., 2001. [DOI]
- H. Massalha, E. Korenblum, S. Malitsky, O.H. Shapiro, A. Aharoni. Live Imaging of Root-Bacteria Interactions in a Microfluidics Setup. Proc. Natl. Acad. Sci. USA, 2017. [DOI | PubMed]
- P.R. Hardoim, C.C.P. Hardoim, L.S. van Overbeek, J.D. van Elsas. Dynamics of Seed-Borne Rice Endophytes on Early Plant Growth Stages. PLoS ONE, 2012. [DOI | PubMed]
- B. Normander, J.I. Prosser. Bacterial Origin and Community Composition in the Barley Phytosphere as a Function of Habitat and Presowing Conditions. Appl. Environ. Microbiol., 2000. [DOI | PubMed]
- D. Johnston-Monje, D.S. Lundberg, G. Lazarovits, V.M. Reis, M.N. Raizada. Bacterial Populations in Juvenile Maize Rhizospheres Originate from Both Seed and Soil. Plant Soil, 2016. [DOI]
- D. Johnston-Monje, W.K. Mousa, G. Lazarovits, M.N. Raizada. Impact of Swapping Soils on the Endophytic Bacterial Communities of Pre-Domesticated, Ancient and Modern Maize. BMC Plant Biol., 2014. [DOI | PubMed]
- A. Pitzschke. Developmental Peculiarities and Seed-Borne Endophytes in Quinoa: Omnipresent, Robust Bacilli Contribute to Plant Fitness. Front. Microbiol., 2016. [DOI | PubMed]
- E.M. Khalaf, M.N. Raizada. Taxonomic and Functional Diversity of Cultured Seed Associated Microbes of the Cucurbit Family. BMC Microbiol., 2016. [DOI | PubMed]
- New Fronteir Data U.S. Cannabis Report: 2019 Industry Outlook
- Z.K. Punja, C. Scott, S. Chen. Root and Crown Rot Pathogens Causing Wilt Symptoms on Field-Grown Marijuana (Cannabis sativa L.) Plants. Can. J. Plant Pathol., 2018. [DOI]
- Z.K. Punja, D. Collyer, C. Scott, S. Lung, J. Holmes, D. Sutton. Pathogens and Molds Affecting Production and Quality of Cannabis sativa L.. Front. Plant Sci., 2019. [DOI | PubMed]
- Z.K. Punja. First Report of Fusarium Proliferatum Causing Crown and Stem Rot, and Pith Necrosis, in Cannabis (Cannabis sativa L., Marijuana) Plants. Can. J. Plant Pathol., 2020. [DOI]
- Z.K. Punja. Flower and Foliage-Infecting Pathogens of Marijuana (Cannabis sativa L.) Plants. Can. J. Plant Pathol., 2018. [DOI]
- Z.K. Punja. The Diverse Mycoflora Present on Dried Cannabis (Cannabis sativa L., Marijuana) Inflorescences in Commercial Production. Can. J. Plant Pathol., 2020. [DOI]
- K. McKernan, J. Spangler, L. Zhang, V. Tadigotla, Y. Helbert, T. Foss, D.R. Smith. Cannabis Microbiome Sequencing Reveals Several Mycotoxic Fungi Native to Dispensary Grade Cannabis Flowers. F1000Research, 2015. [DOI | PubMed]
- E.D. Imolehin. Effect of Fungi on Rice Seed Germination. Plant Dis., 1983. [DOI]
- B. Mitter, N. Pfaffenbichler, R. Flavell, S. Compant, L. Antonielli, A. Petric, T. Berninger, M. Naveed, R. Sheibani-Tezerji, G. von Maltzahn. A New Approach to Modify Plant Microbiomes and Traits by Introducing Beneficial Bacteria at Flowering into Progeny Seeds. Front. Microbiol., 2017. [DOI | PubMed]
- B. Dutta, R. Gitaitis, S. Smith, D. Langston. Interactions of Seedborne Bacterial Pathogens with Host and Non-Host Plants in Relation to Seed Infestation and Seedling Transmission. PLoS ONE, 2014. [DOI | PubMed]
- M. Fürnkranz, B. Lukesch, H. Müller, H. Huss, M. Grube, G. Berg. Microbial Diversity Inside Pumpkins: Microhabitat-Specific Communities Display a High Antagonistic Potential against Phytopathogens. Microb. Ecol., 2012. [DOI | PubMed]
- C. Schluttenhofer, L. Yuan. Challenges towards Revitalizing Hemp: A Multifaceted Crop. Trends Plant Sci., 2017. [DOI | PubMed]
- A. Maity, A. Lamichaney, D.C. Joshi, A. Bajwa, N. Subramanian, M. Walsh, M. Bagavathiannan. Seed Shattering: A Trait of Evolutionary Importance in Plants. Front. Plant Sci., 2021. [DOI | PubMed]
- S. Spaepen, J. Vanderleyden, R. Remans. Indole-3-Acetic Acid in Microbial and Microorganism-Plant Signaling. FEMS Microbiol. Rev., 2007. [DOI | PubMed]
- S. Spaepen, J. Vanderleyden. Auxin and Plant-Microbe Interactions. Cold Spring Harb. Perspect. Biol., 2011. [DOI | PubMed]
- J.M. Bric, R.M. Bostock, S.E. Silverstone. Rapid in Situ Assay for Indoleacetic Acid Production by Bacteria Immobilized on a Nitrocellulose Membrane. Appl. Environ. Microbiol., 1991. [DOI | PubMed]
- J. Wang, X. Wei, M. Kamran, T. Chen, J.F. White, C. Li. Quality and Nutrition of Oat Seed as Influenced by Seed-Borne Fungal Pathogens during Storage. J. Plant Dis. Prot., 2022. [DOI]
- S.K. Verma, K.L. Kingsley, M.S. Bergen, K.P. Kowalski, J.F. White. Fungal Disease Prevention in Seedlings of Rice (Oryza sativa) and Other Grasses by Growth-Promoting Seed-Associated Endophytic Bacteria from Invasive Phragmites Australis. Microorganisms, 2018. [DOI]
- I. Moroenyane, J. Tremblay, E. Yergeau. Soybean Microbiome Recovery after Disruption Is Modulated by the Seed and Not the Soil Microbiome. Phytobiomes J., 2021. [DOI]
- D.S. Lundberg, S.L. Lebeis, S.H. Paredes, S. Yourstone, J. Gehring, S. Malfatti, J. Tremblay, A. Engelbrektson, V. Kunin, T.G. Del Rio. Defining the Core Arabidopsis Thaliana Root Microbiome. Nature, 2012. [DOI | PubMed]
- D.I. Walitang, C.G. Kim, K. Kim, Y. Kang, Y.K. Kim, T. Sa. The Influence of Host Genotype and Salt Stress on the Seed Endophytic Community of Salt-Sensitive and Salt-Tolerant Rice Cultivars. BMC Plant Biol., 2018. [DOI | PubMed]
- D. Johnston-Monje, M.N. Raizada. Conservation and Diversity of Seed Associated Endophytes in Zea across Boundaries of Evolution, Ethnography and Ecology. PLoS ONE, 2011. [DOI | PubMed]
- S.I.M.O. Wills. Cannabis Use and Abuse by Man: An Historical Perspective. Cannabis: The Genus Cannabis, 1998
- C.M. Andre, J.F. Hausman, G. Guerriero. Cannabis sativa: The Plant of the Thousand and One Molecules. Front. Plant Sci., 2016. [DOI | PubMed]
- P. Henry, S. Khatodia, K. Kapoor, B. Gonzales, A. Middleton, K. Hong, A. Hilyard, S. Johnson, D. Allen, Z. Chester. A Single Nucleotide Polymorphism Assay Sheds Light on the Extent and Distribution of Genetic Diversity, Population Structure and Functional Basis of Key Traits in Cultivated North American Cannabis. J. Cannabis Res., 2020. [DOI | PubMed]
- A.J. Mohabeer, P.J. Kaplan, J. Southern, R.M. Gander. Algaemia Due to Prototheca Wickerhamii in a Patient with Myasthenia Gravis. J. Clin. Microbiol., 1997. [DOI | PubMed]
- A.E. Richardson, J.M. Barea, A.M. McNeill, C. Prigent-Combaret. Acquisition of Phosphorus and Nitrogen in the Rhizosphere and Plant Growth Promotion by Microorganisms. Plant Soil, 2009. [DOI]
- L. Bevan, M. Jones, Y. Zheng. Optimisation of Nitrogen, Phosphorus, and Potassium for Soilless Production of Cannabis Sativa in the Flowering Stage Using Response Surface Analysis. Front. Plant Sci., 2021. [DOI | PubMed]
- S. Shiponi, N. Bernstein. The Highs and Lows of P Supply in Medical Cannabis: Effects on Cannabinoids, the Ionome, and Morpho-Physiology. Front. Plant Sci., 2021. [DOI]
- C. Lamb, R.A. Dixon. The Oxidative Burst in Plant Disease Resistance. Annu. Rev. Plant Biol., 1997. [DOI]
- C. Bailly, H. El-Maarouf-Bouteau, F. Corbineau. From Intracellular Signaling Networks to Cell Death: The Dual Role of Reactive Oxygen Species in Seed Physiology. Comptes Rendus-Biol., 2008. [DOI]
- M.G. Ivanchenko, D. Den Os, G.B. Monshausen, J.G. Dubrovsky, A. Bednářová, N. Krishnan. Auxin Increases the Hydrogen Peroxide (H2O2) Concentration in Tomato (Solanum lycopersicum) Root Tips While Inhibiting Root Growth. Ann. Bot., 2013. [DOI | PubMed]
- A. KrishnaMurthy, B. Rathinasabapathi. Oxidative Stress Tolerance in Plants: Novel Interplay between Auxin and Reactive Oxygen Species Signaling. Plant Signal. Behav., 2013. [DOI]
- C. Chen, S. Twito, G. Miller. New Cross Talk between ROS, ABA and Auxin Controlling Seed Maturation and Germination Unraveled in APX6 Deficient Arabidopsis Seeds. Plant Signal. Behav., 2014. [DOI | PubMed]
- S.K. Verma, K. Kingsley, I. Irizarry, M. Bergen, R.N. Kharwar, J.F. White. Seed-Vectored Endophytic Bacteria Modulate Development of Rice Seedlings. J. Appl. Microbiol., 2017. [DOI | PubMed]
- M. Scott, M. Rani, J. Samsatly, J.B. Charron, S. Jabaji. Endophytes of Industrial Hemp (Cannabis sativa L.) Cultivars: Identification of Culturable Bacteria and Fungi in Leaves, Petioles, and Seeds. Can. J. Microbiol., 2018. [DOI | PubMed]
- S.L. Kandel, P.M. Joubert, S.L. Doty. Bacterial Endophyte Colonization and Distribution within Plants. Microorganisms, 2017. [DOI]
- A. Presentato, E. Piacenza, A. Scurria, L. Albanese, F. Zabini, F. Meneguzzo, D. Nuzzo, M. Pagliaro, D.C. Martino, R. Alduina. A New Water-Soluble Bactericidal Agent for the Treatment of Infections Caused by Gram-Positive and Gram-Negative Bacterial Strains. Antibiotics, 2020. [DOI]
- Z.K. Punja. Emerging Diseases of Cannabis sativa and Sustainable Management. Pest Manag. Sci., 2021. [DOI | PubMed]
- R. Kumar, A. Gupta. Seed-Borne Diseases of Agricultural Crops: Detection, Diagnosis & Management, 2020
- A.J. Roberts, Z.K. Punja. Pathogenicity of Seedborne Alternaria and Stemphylium Species and Stem-Infecting Neofusicoccum and Lasiodiplodia Species to Cannabis (Cannabis sativa L., Marijuana) Plants. Can. J. Plant Pathol., 2022. [DOI]
- M. Ongena, P. Jacques. Bacillus Lipopeptides: Versatile Weapons for Plant Disease Biocontrol. Trends Microbiol., 2008. [DOI | PubMed]
- S.A. Cochrane, J.C. Verderas. Lipopeptides from Bacillus and Paenibacillus spp.: A Gold Mine ofAntibiotic Candidates Stephen. Med. Res. Rev., 2014. [DOI | PubMed]
- D.C. Percival, J. Abbey, H. Lu, L. Harris. Use of Biofungicides to Address Conventional Botrytis Blight Control Challenges in Wild Blueberry Production. Acta Hortic., 2017. [DOI]
- N. Matzen, T.M. Heick, L.N. Jørgensen. Control of Powdery Mildew (Blumeria Graminis spp.) in Cereals by Serenade®ASO (Bacillus amyloliquefaciens (Former Subtilis) Strain QST 713). Biol. Control, 2019. [DOI]
- A. Reiss, L.N. Jørgensen. Biological Control of Yellow Rust of Wheat (Puccinia striiformis) with Serenade®ASO (Bacillus subtilis Strain QST713). Crop Prot., 2017. [DOI]
- P.A. Abbasi, B. Weselowski. Influence of Foliar Sprays of Bacillus Subtilis QST 713 on Development of Early Blight Disease and Yield of Field Tomatoes in Ontario. Can. J. Plant Pathol., 2014. [DOI]
- R. Lahlali, G. Peng, L. McGregor, B.D. Gossen, S.F. Hwang, M. McDonald. Mechanisms of the Biofungicide Serenade (Bacillus Subtilis QST713) in Suppressing Clubroot. Biocontrol Sci. Technol., 2011. [DOI]
- E.J. Jo, B.G. Kang, K.S. Jang, Y.H. Choi, J.-C. Kim, G.J. Choi. Control Efficacy of Serenade Formulation against Rhizoctonia and Pythium Damping-off Diseases. Res. Plant Dis., 2014. [DOI]
- D. Comeau, C. Balthazar, A. Novinscak, N. Bouhamdani, D.L. Joly, M. Filion. Interactions between Bacillus spp., Pseudomonas spp. and Cannabis Sativa Promote Plant Growth. Front. Microbiol., 2021. [DOI | PubMed]
- C. Balthazar, A. Novinscak, G. Cantin, D.L. Joly, M. Filion. Biocontrol Activity of Bacillus spp. and Pseudomonas spp. against Botrytis Cinerea and Other Cannabis Fungal Pathogens. Phytopathology, 2022. [DOI | PubMed]
- Z.K. Punja, L. Ni. The Bud Rot Pathogens Infecting Cannabis (Cannabis sativa L., Marijuana) Inflorescences: Symptomology, Species Identification, Pathogenicity and Biological Control. Can. J. Plant Pathol., 2021. [DOI]
- A.S. Monthony, S.R. Page, M. Hesami, A.M.P. Jones. The Past, Present and Future of Cannabis Sativa Tissue Culture. Plants, 2021. [DOI | PubMed]
- D. Caplan, M. Dixon, Y. Zheng. Optimal Rate of Organic Fertilizer during the Flowering Stage for Cannabis Grown in Two Coir-Based Substrates. HortScience, 2017. [DOI]
- D. Caplan, J. Stemeroff, M. Dixon, Y. Zheng. Vegetative Propagation of Cannabis by Stem Cuttings: Effects of Leaf Number, Cutting Position, Rooting Hormone, and Leaf Tip Removal. Can. J. Plant Sci., 2018. [DOI]
- L.G. Campbell, S.G.U. Naraine, J. Dusfresne. Phenotypic Plasticity Influences the Success of Clonal Propagation in Industrial Pharmaceutical Cannabis Sativa. PLoS ONE, 2019. [DOI | PubMed]
- H. Rodríguez, T. Gonzalez, G. Selman. Expression of a Mineral Phosphate Solubilizing Gene from Erwinia Herbicola in Two Rhizobacterial Strains. J. Biotechnol., 2000. [DOI]
- H.R. Shehata, E.M. Lyons, K.S. Jordan, M.N. Raizada. Relevance of in vitro Agar Based Screens to Characterize the Anti-Fungal Activities of Bacterial Endophyte Communities. BMC Microbiol., 2016. [DOI | PubMed]
